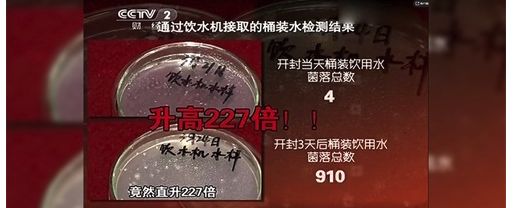

碧水源纳滤净水机让您远离假水威胁,喝上安全健康水
或许您听说过假酒、假包,但您知道吗?现在市面上还有假水横行,全国多地频繁曝出不合格桶装水事件,偷灌自来水、使用黑心桶、细菌超标等现象较为普遍,甚至有饮用桶装水出现农药中毒的案例。种种问题背后都暗藏玄机,给桶装水用户身体健康埋下巨大隐患。更为可怕的是,假冒桶装水仿冒能力极强,普通消费者根本无法用肉眼识别,“假水”带来的危害让人防不胜防。
利欲熏心,假冒桶装水一本万利肆意蔓延
“假水”盛行的背后,竟是巨大利润的驱使。据《中国质量万里行》期刊报道,出售假冒水比出售真正的品牌水带来的利润空间更大。正规桶装水生产工艺有二十多道工序,生产成本高,进货在8元左右,要卖到18元才能有一两元的利润;而出售假水,水站的进货价仅为两元左右,若以18元出售,中间减去水站9元/桶的费用,利润可达7元,甚至更高。面对如此巨大的利润空间,试问哪一家水站能不为之心动呢?
除售卖假水外,更有自制假水的黑心窝点。据央视CCTV13新闻频道报道,上海警察曾查获多家桶装水黑作坊,其中一被告人交代,这些自制桶装水的成本仅在1元左右,贴上知名品牌的商标之后最高可卖到18元每桶,差价高达十几倍。这些自制假水除包装外,基本没有成本支出,但售价却和真水一样,可谓一本万利。

真假难辨,水站店主揭露桶装水内幕
“假水”肆意蔓延的另一个重要原因是消费者对于真假桶装水难以辨别。据《检察日报》报道,某水站店主接受记者采访时表示,市面上的饮用水分为三类,真的品牌水、假的品牌水和杂牌水。其中,假的品牌水大部分是由杂牌水兑成的,即使用自来水,他们也会想办法去掉自来水的味道,在味道上、色泽上不容易与正规品牌水进行区分,即使业内人士也无法辨别。而对于杂牌水,没有防伪标志,生产厂商也不接受水质检查,水源不明。但由于价格低,杂牌水会被很多公司、店铺大量订购,销量巨大。
品牌桶装水真假难辨,杂牌桶装水水源不明,这样的桶装水怎么能让消费者放心饮用呢?
隐患重重,合格桶装水使用不当仍存细菌超标风险
如果您很幸运到正规渠道买到了合格的桶装水,如果使用不当仍存在多重安全隐患。据CCTV-2央视财经《是真的吗》栏目曝光,经国家计量资质认证的检测机构检测数据显示,生产合格的桶装水开封后3天的菌落总数是开封当天的菌落总数的227倍,超过国家标准8倍。菌落总数超标的水可能会导致人体免疫力下降,特别是对易感人群, 如老人、小孩等, 甚至会出现肠胃不适, 呕吐腹泻等症状, 危害人体健康。
同时桶装水还面临使用中的二次污染:饮水机储水桶与饮水机底座连接缝隙较大,使用中如得不到定期清理容易藏污纳垢,造成二次污染,形成安全隐患。此外,桶装水在达到用户家前要经过多个配送环节,无法做到“即滤即饮”,水质不新鲜,容易造成各种菌落超标等现象。而且,桶装水还存在使用成本高、管理不方便等弊端。
饮水有方,碧水源纳滤净水机带来安全健康水
当前,打击“假冒水”现象似乎并无多少良方。假冒水与真水,从表象看,差别不大,普通消费者难以分辨。与其过去、现在和将来稀里糊涂的继续喝“假水”,让身体饱受不安全因素的威胁,不如改变现有的饮水方式,选择安装更安全、更便捷的净水机来保障饮水安全健康。
碧水源纳滤净水机D601,采用碧水源自主创新研发的新一代低压选择性纳滤芯专利技术,能够有效去除有害物质,保留矿物元素,保障水质安全健康;且搭载智能物联技术,通过“高清大屏龙头+手机APP”即可随时了解家中进、出水水质情况和滤芯使用寿命,健康好水看得见,完全打消水质不好的顾虑。使用碧水源纳滤净水机D601还免去自己订水、换水的烦恼,健康好水想喝就喝。
更值得欣喜的是,碧水源纳滤净水机D601运行压力低、通量大,比传统净水机节水约3倍,更省水省电。而且还创新采用节水调节阀,分“100—1000”十档可调,根据家庭原水TDS值,可手动调节浓水排放量,灵活制定个性化节水方案,最大程度为用户节约用水成本。

桶装水各种制假售假的现象屡禁不止,消费者真假难辨,给身体埋下巨大的健康隐患。当下,远离假水威胁的最好方法,便是选择使用更安全、健康、便捷的净水机,碧水源纳滤净水机D601,去害留益,给您带来好水好生活。
网址:碧水源纳滤净水机让您远离假水威胁,喝上安全健康水 https://www.jiaju82.com/news-view-id-678777.html

